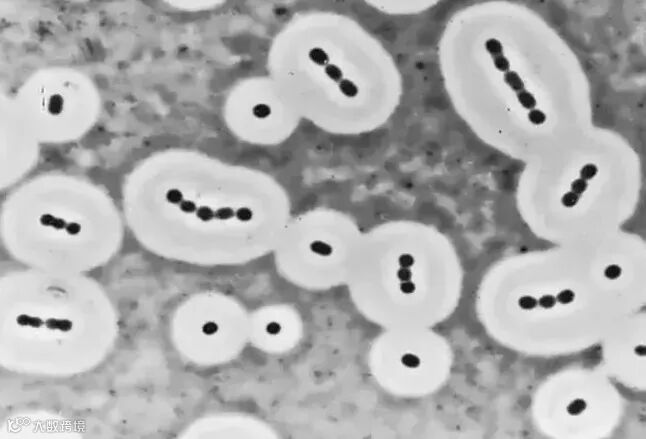

“ 醒醒!你的老婆被蚊子吸走了!!
来自SME
最近你可能在各种社交网络上被大量莫名其妙的梗刷屏。
“给我一把刀,我要见我的血小板老婆!”
“醒醒!你的老婆被蚊子吸走了!”

因为过于喜爱某角色,许多动漫爱好者都习惯性地称他们为自己的老公老婆。
而血小板之所以一夜之间就成为广大“肥宅”们的老婆,全都要归功于一部角度清奇的动画作品《工作细胞》。

这部由漫画改编的动画是日本第一部将人体细胞拟人化的作品,继此前的《兽娘动物园》和《宝石之国》后,担起了“万物皆可萌”的重任。
加上了拟人化的元素,这一部动画番剧可以说将原本复杂晦涩的人体免疫系统讲得有趣又生动。
估计是继蓝猫淘气三千问之后,罕见叫好又叫座的科普动画,实在难得。

《工作细胞》漫画第一话封面(图片来源:网易漫画)
最近更新的第一话,讲了一个肺炎链球菌感染的惊险故事。
主演:红血球、白血球(中性粒细胞)、致病肺炎链球菌。
友情出演:血小板、杀伤性T细胞、巨噬细胞、树状细胞、辅助性T细胞、调节性T细胞。
剧情(无剧透):迷路红血球四处乱撞遇上肺炎链球菌感染,被白血球偶遇且英雄救美,惊险刺激又热血肺疼的故事。

听起来是一个简单又老套的故事,但在现实中,就算是最常见的细菌感染,也是一个究极复杂的过程。
而动画中描述的肺炎链球菌可以说并不普通,虽然它极为常见,甚至很多健康的人体都会携带。

动画中的肺炎链球菌形象
一般情况下,肺炎链球菌会寄居人体鼻咽处,利用表面的黏附素紧贴呼吸道的上皮细胞。
在春冬交替的时候,一旦人体出现免疫力下降,或者被流感侵入,肺炎链球菌就会趁虚而入。
它除了像名字那样引起肺炎之外,还会造成很多危险的病症,比如脑膜炎、骨髓炎、心内膜炎、腹膜炎、心囊炎等。
根据WHO估计,全球范围内肺炎链球菌每年导致上百万人死亡,以免疫力较弱的老人小孩为主,9成发生在欠发达地区。

肺炎链球菌经革兰氏染色法染色呈蓝紫色,动画中也取相近的颜色
根据肺炎链球菌的特性,通常最先入侵的就是肺部组织,进入血液循环后会入侵其他器官。
病菌一旦入侵,最先引起中性粒细胞的警觉。
中性粒细胞是白血球中最多的一种,是人体的第二道防线,对异常的化学物质刺激非常敏感,还能够自由在血管内外游走。

所以主角白血球的拟人化设定就是神出鬼没,嗅觉灵敏,总是能在案发第一现场看见他在战斗。
在女主角红血球受到生命威胁时,男主角挺身而出消灭反派是非常合理的设定。
只是中性粒细胞对病菌的攻击手段就和动画里所描述的有很大的出入了。
中性粒细胞对付外来入侵物的方式描述起来可能会有莫名的萌感。

你心中的中性粒细胞 VS 真实的中性粒细胞
首先中性粒细胞感受到化学刺激便会向着浓度高的方向移动,称为趋化作用,当受体与趋化因子发生结合,中性粒细胞便会伸出伪足,抓住它要吞噬的物质。
伪足向内凹陷,逐渐将异物包裹进而吞噬近细胞膜内,再通过细胞内各种酶轮番轰炸,最后消灭病菌。
所以中性粒细胞的战斗方式不应该是像动画里那样拿着匕首横冲直撞,而应该是伸着小手快步追击,抓到病菌以后直接用手把它吞进体内。

中性粒细胞吞噬细菌
当然,中性粒细胞的工作也不总是那么顺利的,有很多细菌是有备而来,像肺炎链球菌就带了专业的装备。
动画里肺炎链球菌放出烟雾抛出网状的荚膜,成功束缚住中性粒细胞和红血球,然后伺机逃跑。
虽然这样描述比较通俗易懂,但荚膜真实的作用是相当复杂的。

荚膜是包裹在细菌最外层的一种特殊结构,就肺炎链球菌而言,荚膜是由单糖连接成的聚合体,含有大量的水分。
有了荚膜的肺炎链球菌战斗力和生存力都有质的飞跃,直接导致包括中性粒细胞在内的吞噬细胞难以与细菌表面的受体结合,进而抵抗了吞噬作用。

肺炎链球菌细胞壁外有明显的荚膜结构
用大白话解释起来,荚膜的抗吞噬作用可能更像是一种永久生效的自带烟雾效果,让中性粒细胞看不清又抓不到。
顺带一提,细菌荚膜的厚度直接影响其破坏力,致病力强的病菌往往有更厚的荚膜。
但荚膜的状态也不会一成不变,在生存压力较小的环境下培养,肺炎链球菌的荚膜会变薄,甚至完全丢失变得无害,有点生于忧患死于安乐的意思。
变形链球菌拥有非常厚的荚膜,它的存在是导致龋齿的重要因素
纵使带了装备的肺炎链球菌能躲过中性粒细胞的追捕也离成功还很遥远。
动画中主要篇幅都花在了中性粒细胞与红血球之间的故事线,对其他认真工作的细胞们有些冷落。

白血球、红血球与血小板(电镜图白血球为淋巴细胞)
比如一闪而过的巨噬细胞,它是奋斗在非特异性免疫第一线的死神。
不仅会无差别地收割那些外来的入侵者,也会给已经死亡的细胞“收尸”,同时采集入侵者的抗原。
因为威力巨大,每个巨噬细胞能吞噬多达100个入侵者,往往轮不到其它免疫细胞出手,就能解决战斗。

巨噬细胞
又比如存在感较低的树突状细胞,它是免疫系统中最重要的抗原呈递细胞。
树突状细胞通常分布在与外界接触的粘膜或皮肤组织上,也以未成熟的形式在血液中游走,专职吞噬并处理抗原,相当于奋斗在一线的情报专家。

树突状细胞
有了这些细胞的前期准备,我们与细菌的战争才能从防御性反抗的非特异性免疫进入全面反击状态。
反击由淋巴细胞发起,辅助性T细胞与抑制性T细胞激活调节战斗,而主力部队由杀伤性T细胞担当。

动画中,杀伤性T细胞被塑造成身着黑色制服身强力壮的特工,并且面目狰狞甚至有些不太友好。
甚至对主角红血球说了一番带有恐吓意味的言语,原因作者没有多做说明。
杀伤性T细胞如此凶神恶煞也是有根据的,因为杀伤性T细胞还并非对外作战的部队,而更像是内部维稳的警察。

它们所杀伤的是那些出现异常的体细胞,包括被感染细胞或癌细胞,正所谓攘外必先安内。
如果杀伤性T细胞出现了不受控制或者调节紊乱的情况,可能会攻击正常的体细胞,常见于自身免疫病。
所以动画中其它细胞对杀伤性T细胞的态度是十分敬畏的,这微妙的关系把握得很好。

正在攻击癌细胞的杀伤性T细胞
鉴于动画中肺炎链球菌的感染程度比较轻微,此后更为复杂的细胞免疫以及体液免疫就暂不涉及了。
值得一谈的是,动画第一集最后男女主角不舍的告别。

红血球腼腆又忧心地问:“那个……白……白血球先生,我…我们还会见面吗?”
白血球先生充满希望的说:“我们都在同一个世界工作,总有一天会再见的。”
然而,有必要打醒沉迷情感剧情的观众们,你们体内的红血球和中性粒细胞是不会发生任何故事的。

中性粒细胞战斗后留下的脓
在免疫一线作战的中性粒细胞通常并不是虐菜一样杀死病菌,吞噬病菌之后中性粒细胞也会死亡。
死亡的中性粒细胞堆积在一起形成了凝乳状的液体,也就是常见的那些黄绿色的脓。
所以非要较真的话,英雄救美的故事不但不会发生,甚至还会发生一些悲剧。

系统性红斑性狼疮是一种严重的自身免疫病
中性粒细胞因为过于勇猛,它们在清除病菌的同时甚至会杀伤无辜的健康细胞。
因此,这些残暴的中性粒细胞的寿命被控制在几天以内,与寿命120天的红血球没有可比性。
爱上中性粒细胞的红血球只有两种下场,成为寡妇或者双双殉情,最后被巨噬细胞当作垃圾收走。

《工作细胞》是一部优秀的科普作品,但关于免疫系统的知识还是非常简化的,为了主线的剧情不得不忽略掉一些事实。
作品本身的意图还是想通过拟人化的剧情给广大动画漫画爱好者带来一点新鲜的科普血液。
当你的生活跌到谷底,没有希望满是沮丧,想一想自己身体里辛勤工作的细胞们吧,它们每天都要面对甚至更棘手的危机。
你还有什么理由不好好工作好好学习呢?
*参考资料
王楷宬,陆承平,范伟兴.细菌荚膜多糖[J].微生物学报,2011,51(12):1578-1584.
刘茹,田琴琴,张光莉,邹心,周干,陈明,孟庆清,董世访,罗征秀.肺炎链球菌肺炎对肺部树突状细胞及CD4~+T细胞的影响[J].免疫学杂志,2016,32(04):288-293.
魏桂芳,沈荣.肺炎链球菌相关毒力因子及其作用的研究进展[J].微生物学免疫学进展,2016,44(05):69-75.
中性粒细胞、肺炎链球菌、T细胞、免疫细胞,维基百科.
The Immune System Explained I – Bacteria Infection. Kurzgesagt – In a Nutshell. Youtube.
更多精彩文章关注仪器+资讯平台:yqj.mumuxili.com
买耗材仪器,找木木西里:www.mumuxili.com
正版印度神药为何这么贵?研究半世纪,两夺世界第一,出了五位顶级医学奖
特别声明:本文发布仅仅出于传播信息需要,并不代表本公共号观点;如其他媒体、网站或个人从本公众号转载使用,请向原作者申请,并自负版权等法律责任。





